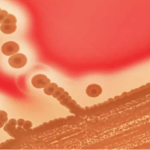
انتشار وباء مميت في اليابان

نداء رئيس الوزراء لتقديم دعم مالي للسلطة الفلسطينية
نداء رئيس الوزراء لتقديم دعم مالي للسلطة الفلسطينية حيث طالب رئيس الوزراء ووزير الخارجية والمغتربين، محمد مصطفى، المجتمع الدولي بالتدخل العاجل لمعالجة الأزمة المالية والضغط على إسرائيل لوقف قرصنة أموال الضرائب وإعادة الأموال المحتجزة، وتوفير حزمة دعم مالي طارئة ومباشرة للميزانية، وللحماية الاجتماعية للأسر الفقيرة والعمال الذين فقدوا وظائفهم بسبب العدوان، بالإضافة إلى تسديد متأخرات القطاع الخاص المتراكمة.
وفي كلمته خلال الاجتماع الوزاري لشركاء فلسطين الدوليين في بروكسل،
أكد مصطفى أن الحصار المالي يشكل انتهاكًا للقوانين والاتفاقيات الدولية، وأن انخفاض الإيرادات العامة والاقتطاعات الإسرائيلية من الضرائب تضر بقدرة الحكومة على تلبية احتياجات الشعب.
أشار إلى أن الحكومة تعمل حاليًا على خطة للإغاثة العاجلة والإنعاش المبكر لدعم 2.2 مليون مواطن في غزة،
تشمل تدخلات فورية وتعافي مبكر بالتنسيق مع الشركاء.
وأكد على أهمية الإصلاح الإداري والمؤسسي لتحسين جودة الخدمات وتعزيز الشفافية وتحقيق التنمية الاجتماعية والاقتصادية.
وختم كلمته بالحديث عن توفير دعم مالي لأكثر من نصف مليون عاطل عن العمل في الضفة الغربية وغزة،
محذرًا من خطورة الإجراءات الإسرائيلية ضد المؤسسات المصرفية الفلسطينية وتأثيرها السلبي على الوضع الاقتصادي.